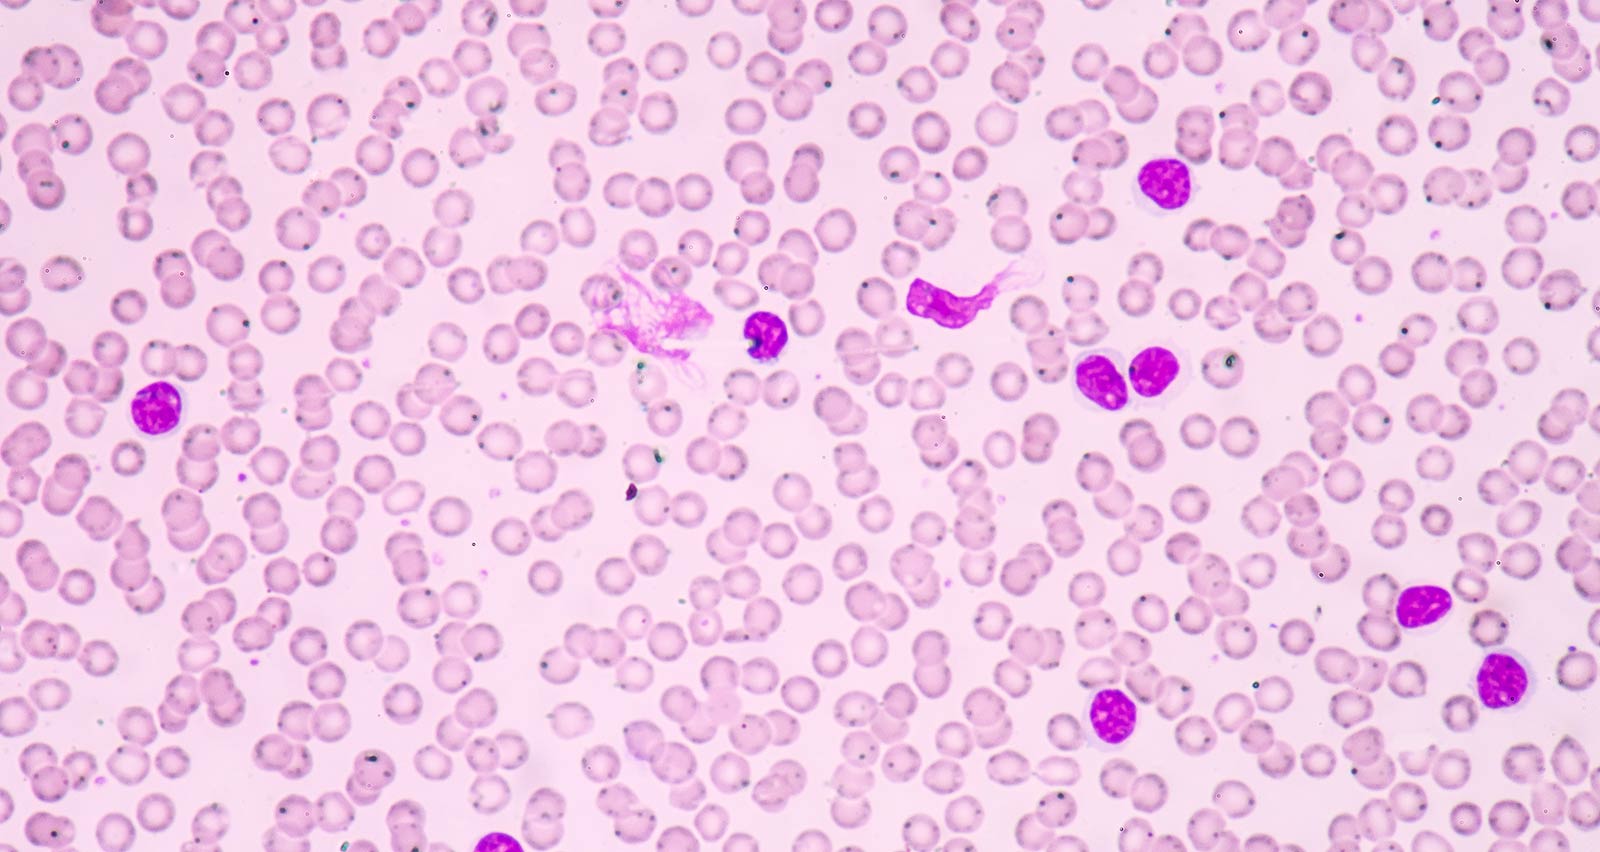

What Is Chronic Lymphocytic Leukemia (CLL)/Small Lymphocytic Lymphoma (SLL)?
Chronic Lymphocytic Leukemia (CLL) is a cancer that starts in B lymphocytes, which are part of the immune system. B lymphocytes live in the bone marrow, blood and the lymph nodes. When a patient develops CLL, these cells grow in an uncontrollable fashion. When the majority of these abnormal cells are in the blood, we call the disease chronic lymphocytic leukemia (CLL). When most of the abnormal cells are in the lymph nodes, we call it small lymphocytic lymphoma (SLL). In many patients both blood and lymph nodes are involved, and the terms CLL and SLL are practically interchangeable.
CLL/SLL is the most common leukemia diagnosed in adults. Because the leukemia cells in CLL/SLL often build up slowly, many people do not present with any symptoms for at least a few years after getting the disease. Some patients never develop symptoms nor do they require treatment. But in others, over time, the CLL cells can grow and spread to other parts of the body, including the lymph nodes, liver and spleen.
Your health is important. Get expert care.
Offering in-person, video and telephone visits. Call 216-844-3951 today to see which option is right for you.
Learn more about virtual visitWhat Causes Chronic Lymphocytic Leukemia?
Like other cancers, CLL is caused by changes (mutations) in the genetic material (DNA) of certain cells. Cancer-causing mutations often occur in genes that regulate the growth and division of cells or genes that normally keep cell division in check and ensure that cells die at the right time. CLL occurs when B-cell lymphocytes begin to divide uncontrollably. However, in most cases, doctors do not know what prompts the mutations to occur.
The mutations that lead to CLL are generally thought to happen randomly over the course of a person’s lifetime. The disease is rarely caused by mutations inherited from parents, though some inherited mutations may increase a person’s risk of developing CLL. Factors that can raise the risk of CLL include:
- Age: CLL occurs most often in older adults.
- Family history of blood and bone marrow cancers: A family history of CLL or other blood and bone marrow cancers may increase your risk.
- Having monoclonal B-cell lymphocytosis (MBL): MBL is a condition that causes an increased number of B-cell lymphocytes in the blood. Most patients with MBL remain asymptomatic, but a small percentage develop CLL.
Signs and Symptoms of Chronic Lymphocytic Leukemia
Many people with CLL have no symptoms at first. Signs and symptoms that can develop as the cancer progresses include:
- Enlarged but painless lymph nodes
- Fatigue
- Fever
- Spleen enlargement – can lead to feeling of fullness in the abdomen
- Night sweats
- Weight loss
- Frequent infections
Note that other cancers and illnesses can cause these symptoms. Make sure to inform your doctor about any symptoms of disease you may have.
How Is Chronic Lymphocytic Leukemia Diagnosed?
Some patients with CLL/SLL are diagnosed during a routine blood test or physical exam. Physicians can largely predict the course of an individual patient’s disease by analyzing certain characteristics of the abnormal cells, and in some cases, by observing changes in blood counts or the size of the lymph nodes.
Procedures and tests used in the diagnosis of CLL/SLL include:
- Physical exam: Your doctor will examine you to check your vital signs. They will also feel your lymph nodes, spleen and abdomen to see if any enlargement is present. In addition, your doctor will also ask you about your family medical history and your own general health.
- Blood tests, including:
- Complete blood count: A complete blood count may be used to count the number of lymphocytes in a blood sample. A high number of B-cells, one type of lymphocyte, may indicate CLL.
- Immunophenotyping by Flow Cytometry: To determine the type of lymphocytes involved, a test called immunophenotyping by flow cytometry can determine whether an abnormally high number of lymphocytes is due to CLL, a different blood disorder or your body’s reaction to an infection or other illness. If a CLL diagnosis is confirmed, this test can help predict how aggressive the leukemia cells will be.
- Fluorescence In Situ Hybridization (FISH): This blood test looks for changes in the chromosomes inside the cancerous lymphocytes. Your doctor may use this information in your prognosis and in determining the best treatment plan.
- Molecular Testing: Molecular testing allows physicians to detect certain mutations that are involved in the growth of CLL and help with prognosis.
- Other tests: In some cases, your doctor may order additional tests and procedures to aid in diagnosis, such as:
- Bone marrow test (bone marrow aspiration and biopsy): : During this test, a needle is used to obtain a bone marrow sample from the hipbone. Lab analysis will classify the blood cells in the marrow sample and identify and characterize leukemia cells. In CLL/SLL, similar cells are often present in the blood, but the marrow test yields more accurate information than blood testing.
- Imaging tests: Imaging tests use x-rays, sound waves or magnetic fields to produce pictures of structures inside the body. While not used in the diagnosis of CLL, imaging tests may be ordered for other reasons, such as to view a suspicious area in the body that could be a solid tumor, learn if and how far the cancer has spread outside of the blood, and to help assess if a treatment is working.
How Is Chronic Lymphocytic Leukemia Treated?
Some patients with CLL never need treatment. In other cases, the disease can steadily worsen, and treatment is needed.
Individual treatment of CLL depends on the stage of the disease and the patient’s symptoms and overall health, among other factors. Because CLL often progresses slowly, not everyone needs to be treated immediately. If your CLL does not cause symptoms and does not show signs of getting worse, your doctor may recommend delaying treatment of the disease, but have you come in for regular checkups and blood tests to monitor your condition.
If your doctor determines your CLL requires treatment, options may include:
- Chemotherapy
-
Chemotherapy refers to the use of drugs to kill cancer cells. Most often, chemotherapy drugs are injected directly into a vein, a muscle or under the skin, or else taken orally. By entering the bloodstream, chemotherapy drugs are able to reach leukemia cells all throughout the body.
- Targeted Drug Therapy
-
Targeted drug therapy is a treatment method that utilizes drugs or other substances to identify and attack specific cancer cells. In general, targeted therapies are less harmful to healthy cells than standard chemotherapy or radiation therapy.
- Immunotherapy and CAR T-Cell Therapy
-
Immunotherapy is a newer approach to treating cancer that harnesses the body’s own natural defenses to fight the disease. Your body’s immune system may not attack your cancer cells because they produce proteins that help them hide from immune system cells. Immunotherapy works by disrupting that process.
UH Seidman Cancer Center is one of the few academic medical centers in the country to produce cell-based immunotherapies on-site. On-site production lets us to make cell-based therapies more quickly and at a lower cost than what is available commercially.
- Bone Marrow Transplant
-
A bone marrow transplant, also known as a stem cell transplant, replaces leukemic bone marrow with leukemia-free marrow from a healthy donor to allow the patient to reestablish healthy bone marrow. The transplant is performed after high doses of chemotherapy or radiation are employed to destroy leukemia-producing bone marrow.
As novel and more-effective drug combinations have been developed to treat CLL, bone marrow transplant has become less common in treating the disease. However, in certain situations, the procedure may be a useful treatment option.
Chronic Lymphocytic Leukemia Prognosis
Though CLL can rarely be cured, it has a higher survival rate than many other cancers. The 5-year survival rate for adults with CLL ages 20 and older is around 87 percent; this means that 87 percent of people with CLL are alive 5 years after diagnosis.
Most people live with the disease for many years. Survival rates vary depending on a number of factors, including the stage of the disease and the age and overall health of the patient. While some individuals with CLL can live for years without treatment, most people with the disease will eventually require treatment.

Clinical Trials Available for Chronic Lymphocytic Leukemia and Other Types of Lymphoma
Access to innovative treatments, including lymphoma-specific clinical trials with targeted agents, gives patients more treatment options. We offer new therapies that are safer, more tolerable and more targeted to help differentiate lymphoma cells and minimize side effects. Our physicians are the principal investigators for many of these cancer clinical trials, offering hope to both newly diagnosed lymphoma patients and those who have relapsed.
Clinical Trials for Lymphoma
Giving to UH Seidman
Make a gift today to support lymphoma research and patient care at UH Seidman Cancer Center.
Ways To Give

